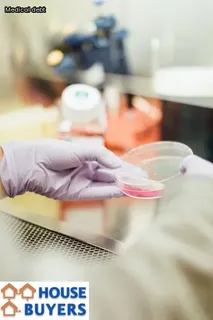
can hospital take your house

For residents of Washington DC, medical bills can be a major burden. Unfortunately, if left unchecked, they can even put your home at risk of foreclosure.
To prevent this from happening, it is important to understand what options are available to District residents for eliminating or reducing their medical debt. The District offers a number of programs and initiatives that can help individuals who have incurred medical debt qualify for relief.
These include Medicaid expansion, the Health Benefit Exchange Program, and the Medical Debt Relief Program. Each program has its own criteria and qualification process which must be met in order to receive assistance in eliminating or reducing the amount owed for medical services.
Additionally, there are several non-profit organizations that offer assistance with medical debt relief specifically for District residents. It is essential to take advantage of these resources when facing significant medical debt so as to avoid potential foreclosure on one's home.

The Executive Office of the Mayor (EOM) in Washington D.C. is committed to supporting residents who are struggling with medical debt.
The EOM provides access to a variety of resources that can help minimize the financial burden associated with medical bills and protect homeowners from foreclosure due to unpaid debts. Some resources include free legal advice from qualified attorneys, assistance with loan modification, and credit counseling services that can provide guidance on budgeting and debt repayment strategies.
Homeowners facing foreclosure can also take advantage of mediation services offered by the EOM that can bring lenders and borrowers together to negotiate a resolution for medical debt repayment. Through these programs and services, the EOM helps the residents of Washington D.C. have peace of mind knowing that they have options to protect their real estate investments from medical debt-related foreclosures.
When a person dies, their medical debt does not necessarily disappear. Depending on the situation, the deceased's estate or the family of the deceased may be held responsible for any remaining medical bills.
It is important to understand who is responsible for these debts and what rights they have in order to protect their real estate from being taken away due to unpaid medical bills. Generally speaking, if the deceased was insured, then the insurance company will be expected to cover any costs owed to medical providers.
If there are no assets in their estate, such as cash or real estate, then creditors can usually not take any action against them. However, if the deceased had any assets at the time of death that could be used to pay off debts, such as a house in Washington D.C., then those assets may become subject to claims by creditors seeking payment on outstanding debts.
In this case, it is important for family members or other representatives of the deceased's estate to understand their rights and responsibilities regarding any potential medical debt owed so that they can protect real estate from being taken away due to unpaid medical bills.

When someone dies, it can be difficult to handle all of the financial responsibilities they left behind. While medical bills are one type of debt that needs to be addressed, there may also be other types of debts that need to be handled as well.
These include credit card debt, student loans, and any other loans taken out during a person's lifetime. In some cases, the deceased person may have co-signed for a loan or had joint accounts with another individual, so those will also need to be dealt with following their death.
Additionally, any assets that were held jointly also need to be addressed in order to ensure that all debts are paid off as soon as possible. Depending on where the deceased resided and the laws in place at the time of their death, their estate may also be responsible for paying off any remaining debts after their death.
It is important for family members and close friends to understand all of the various types of debts that may arise when someone passes away in order to ensure that everything is properly taken care of.
When a loved one passes away, it can be hard enough to cope with the grief and other emotions without having to worry about financial matters. However, it is important to notify creditors that a death has occurred in order to protect the estate from medical debt.
This can help prevent creditors from attempting to secure repayment for medical bills through legal or collection actions, such as seizing real estate. When possible, it is best to contact creditors directly or, if that is not an option, provide proof of death with a certified copy of the death certificate when communicating with them.
It may also be necessary for family members or representatives of the deceased person's estate to seek guidance from a lawyer or other qualified professional on how best to handle medical debt after a death occurs.
When a loved one passes away with medical debt, it can have a negative impact on the credit of those left behind. Many times, an individual’s debt is transferred to their estate after death.
If this estate does not have enough assets to cover the costs, it could then be passed to the individuals inheriting the estate. This means that creditors may come after the beneficiaries for repayment of medical bills, and failure to pay these debts can result in damage to your credit score.
It is important to understand how creditors will approach a deceased person’s debts and how you can protect yourself from becoming responsible for them.
It is important to understand the laws and regulations in Washington D.C. that protect your estate and heirs from medical debt.
Medical bills can be difficult to manage, but there are ways to ensure that you and your family are protected in the case of a major medical expense. If you are facing financial hardship due to a medical event, it is important to first assess the situation and create a plan of action for addressing the debt.
It is also important to know what resources are available, such as government programs or legal assistance, which can help reduce or eliminate some of the financial burden associated with medical bills. Additionally, if a loved one passes away leaving behind unpaid medical bills, it is important to understand how those debts will be handled under state laws so that your heirs do not have to bear additional financial responsibility.
Finally, having an estate plan in place can help protect assets from creditors before any issues arise related to medical debt. Being proactive and understanding your options can provide peace of mind when navigating through a difficult situation like medical debt.

In Washington DC, medical bills are a serious issue. It is possible for them to take a person’s house if not managed properly. Understanding the risk of this debt is critical for those living in the nation’s capital.
The first step is to be aware of what medical bills can do and how they are enforced. Medical debt is one of the leading causes of foreclosure in the United States, and it has become even more prevalent during the pandemic due to job losses and other financial issues. In Washington DC, there are specific laws that govern how and when creditors can try to collect on unpaid medical debts.
Knowing these rules can help individuals protect their assets from being taken away by creditors because of medical bills. To start, it is important to review your credit report regularly for any unpaid medical bills that may have been sent to collections or incurred through recent hospital visits or treatments. If any such items appear on your report, it is essential to contact the creditor directly and negotiate a payment plan before they can take legal action against you.
Additionally, there are resources available in Washington DC that offer assistance with paying off medical debts, such as government programs or nonprofit organizations that provide grants and loans. Lastly, filing for bankruptcy may be an option for those facing significant amounts of medical debt but should only be considered as a last resort after all other options have been exhausted.
When it comes to unpaid medical bills, customers in Washington D.C. may be concerned about the legal implications of their debt on their real estate.
Fortunately, there are several options available to dispute and resolve medical bills without risking the loss of one's house. Depending on the individual circumstances, consumers have access to debt relief programs that can help them manage their medical debt, as well as dispute resolution services through consumer protection agencies such as the Washington D.C.
Office of the Attorney General and the Department of Insurance, Securities and Banking (DISB). Additionally, filing a complaint with HealthCare.gov or collaborating with a trusted lawyer can be good alternatives for those looking for more personal assistance with unpaid medical debts.
Taking advantage of these resources is key in order to protect one's real estate from being taken away due to an inability to pay medical bills.

When it comes to medical bills, there is a lot of confusion surrounding how taxes will factor into the equation. Fortunately, when paying off medical debt in Washington D.C., there are some options available to help minimize tax liability.
For instance, taxpayers can deduct medical expenses from their federal income tax return if they exceed 10% of their adjusted gross income (AGI). Additionally, any interest paid on loans taken out to pay for medical expenses is tax-deductible up to a certain amount.
Furthermore, payments made using a Health Savings Account (HSA) or Flexible Spending Account (FSA) are not taxable and can be used to pay for qualified medical expenses without incurring additional tax liability. It’s important to note that if one withdraws from either account for non-medical expenses, then they may be subject to additional taxes as well as a potential penalty.
Finally, those who have outstanding accounts with their healthcare provider may qualify for financial assistance or payment plans that can help reduce the overall cost of medical services and potentially lower the amount owed in taxes. Taking the time to understand the various options available when it comes to paying off medical debt can help ensure that taxpayers protect their real estate and minimize any potential tax liability along the way.
For families in Washington D.C. facing the threat of having their home taken away due to medical bills, there are several potential solutions available for protection and relief.
Speaking with a financial advisor or credit counselor is a good first step; they can provide advice on budgeting and debt management, as well as possible assistance through a debt consolidation program that can reduce monthly payments and interest rates. Additionally, it's important to research state and federal laws regarding medical debt, which may offer additional tools for payment relief such as forbearance or deferment options.
Many states also have nonprofit organizations that provide free legal services to individuals struggling with medical debt, providing assistance with negotiations with creditors and other resources. Finally, Washington D.C., like most states, has consumer protection laws in place to protect citizens from unfair collection practices by debt collectors; understanding these laws can help ensure rights are not violated when dealing with medical debts.

Filing for bankruptcy is an option to erase or reduce your medical debt if you are a Washington D.C. resident.
Depending on the type of bankruptcy filed, either Chapter 7 or Chapter 13, certain debts may be eligible to be discharged or paid back over time. If you qualify for Chapter 7 bankruptcy, all unsecured debts such as medical bills can be wiped out without repayment.
With Chapter 13, your medical bills can be part of the payment plan and you will have several years to pay off the debt at a reduced interest rate. It is important that you research and understand all the requirements and qualifications for each type of bankruptcy before filing so that your situation can be assessed in accordance with current laws.
Additionally, it is wise to consult with a financial professional to gain insight into how filing for bankruptcy would impact your credit score and other areas of your life.
Federal law does provide protection against harassment from bill collectors when it comes to unpaid medical debts. The Fair Debt Collection Practices Act (FDCPA) prohibits debt collectors from using abusive, threatening, or deceptive practices when collecting consumer debts.
This includes any form of verbal abuse, false statements made about the person's debt, or threats of legal action. It is illegal for debt collectors to contact you before 8:00am and after 9:00pm local time, or at other inconvenient times or places.
Additionally, they are not allowed to make any kind of contact with you more than once a week unless you have specifically requested it. If a debt collector has violated any of these rules, you can take legal action against them by filing a complaint with the Federal Trade Commission (FTC).
While federal law does provide some protection for consumers dealing with medical debt, it is important to note that there are certain types of medical bills that cannot be discharged through bankruptcy and will remain on your credit report for up to seven years. In order to protect yourself from potential medical debt collection problems in the future, it is important to keep track of your bills and make sure that all payments are made on time.
The statute of limitations for medical bills in Washington state is three years – meaning creditors have three years from the date a bill was due to initiate legal action. This three-year period is used to determine how long creditors can legally pursue debtors for payment on delinquent medical bills.
It’s important for Washington D.C. residents to understand the statute of limitations when it comes to medical debt, as failure to pay medical bills can result in property liens being placed on their real estate and potentially losing their house.
Knowing this information can help protect one’s real estate from becoming collateral damage in the fight against medical debt.

Medical collections can have a significant impact on your ability to get a mortgage. If you have unpaid medical bills in Washington D.C., creditors may be able to take your home if you default on repayment for these bills.
The best way to protect your real estate from medical debt is by understanding the laws regarding collection efforts and foreclosure in the District of Columbia. Knowing the rules can help prevent creditors from taking action against you and your property.
Negotiating with medical debt collectors may also be an option, as they may be willing to settle for less than what is owed or create more flexible payment plans that work with your budget. Lastly, it’s important to stay on top of all payments and make sure your credit score stays in good standing, as this will play an important role in qualifying for a mortgage loan.
Medical debt can be a major burden, especially for those living in Washington D.C. who are facing the prospect of losing their home due to medical bills.
Fortunately, there are options available to help ease that burden and even forgive medical debt in some cases. For instance, many creditors may be willing to negotiate a payment plan or reduce the amount owed in order to make the debt more manageable.
Additionally, if you have a low income or meet certain other qualifications, you may qualify for programs such as Medicaid, which can provide assistance with medical bills. Finally, filing for bankruptcy can also eliminate medical debt in some cases.
When considering these options, it is important to consult a financial advisor or attorney to determine what best fits your situation and maximize your chances of having your medical debt forgiven or reduced.
If you can't pay your medical bills in America, it is important to be aware of the potential consequences. Depending on the state where you live, failure to pay medical debt could put your real estate at risk.
In Washington D.C., for example, it is possible for unpaid medical bills to lead to a lien being placed on your property; if this happens and the debt is not paid off, foreclosure may be the result. To protect yourself from falling into such a situation, it is important to understand how medical debt works and what options are available when you find yourself unable to pay.
Taking proactive steps such as speaking with a financial advisor or contacting an attorney can help you stay ahead of any potentially serious consequences resulting from unpaid medical bills.
A: No, medical debt cannot result in a patient's house being taken away in Washington DC, regardless of whether or not they have American health insurance coverage.
A: The lack of health care coverage in Washington DC can lead to an inability to pay medical bills, which can then result in the loss of a patient's house. This contributes to health inequities and disparities, as those without access to American health care are more likely to experience negative outcomes due to their inability to cover necessary medical expenses.
A: Yes, unpaid medical bills can be reported to a credit bureau or creditor and damage the patient's credit record. This is because medical care providers have contracts with these companies to report information about payments.